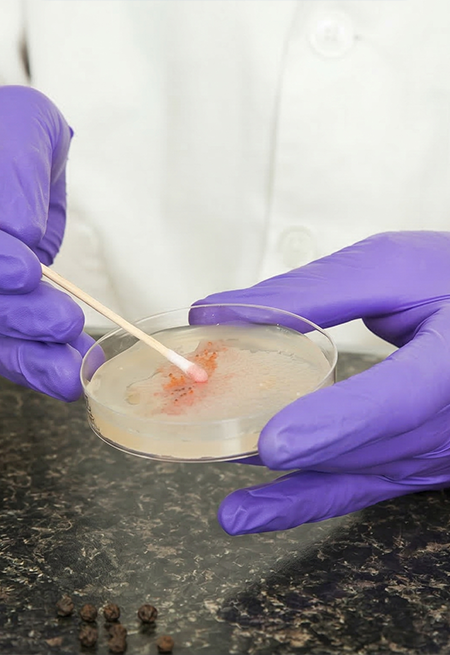
Swab

Análises laboratoriais com responsabilidade ambiental
Referência em ensaios analíticos para o meio ambiente e a saúde.
Somos um laboratório especializado em análises ambientais e de controle de qualidade.
Oferecemos serviços de amostragem e ensaios físico-químicos e microbiológicos, com foco em monitoramento ambiental, saúde pública e conformidade regulatória. Atuamos em diversos segmentos e atendemos diversas matrizes, como águas, alimentos, cosméticos, solos e resíduos, garantindo resultados confiáveis e rastreáveis.